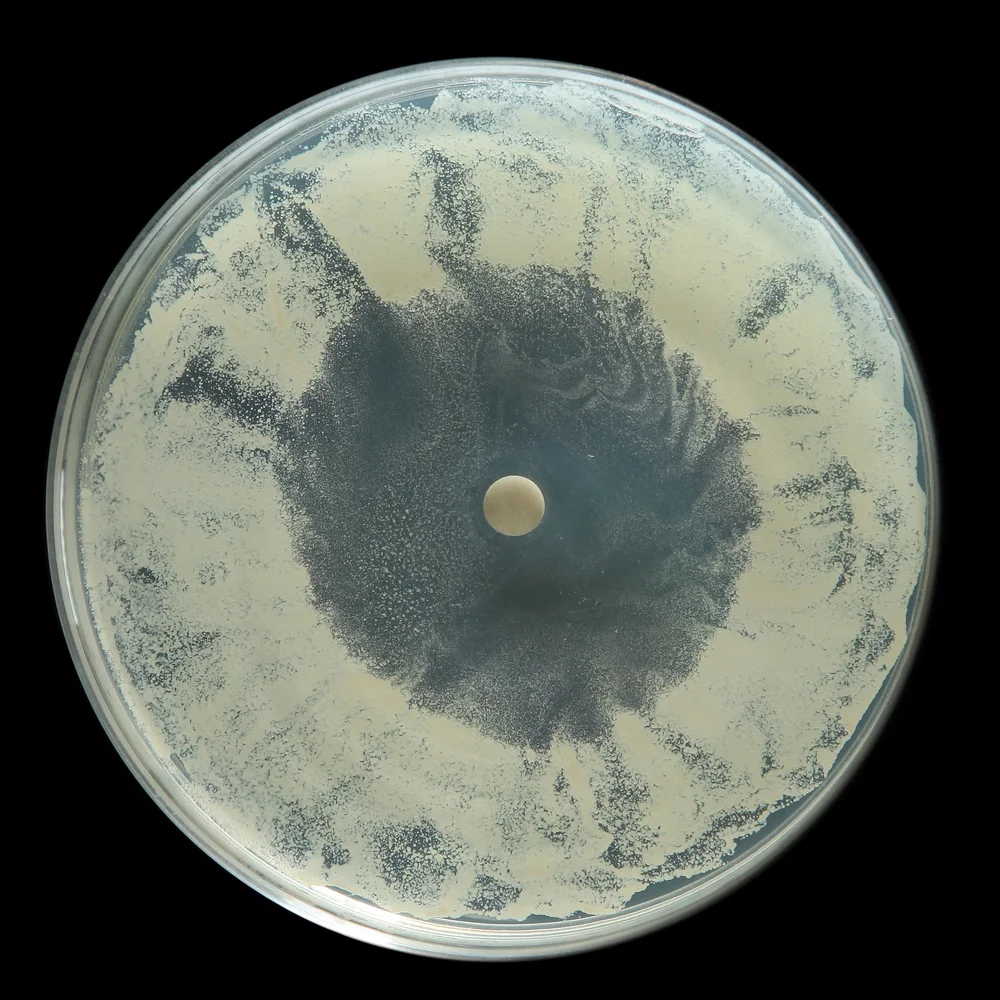

חדשות
מבלי שמדברים על כך הרבה, בבתי החולים בארץ מתפשטת בשנתיים האחרונות פטרייה מדבקת ואלימה במיוחד בשם "קנדידה אאוריס" - המציבה בסכנה ממשית בעיקר בעלי מערכת חיסון חלשה וחולים מאושפזים המחוברים למכשירים בבתי החולים. המחלה עלולה להיות קטלנית ולגרום סיבוכים ואף מוות. קטי דור חשפה לראשונה ב'כאן 11', כי מדובר במחלה בעלת שיעורי תמותה גבוהים במיוחד.
מנהל היחידה למחלות זיהומיות בבית החולים איכילוב ומנהל המעבדה המרכזית לחקר הפטריות, פרופסור רונן בן עמי, ביצע מעקב אחר נתוני המחלה בשנים האחרונים ומזהיר כעת כי מדובר בפטריה אלימה ומסוכנת, המגיעה ל-40% בשיעור התמותה בקרב הנדבקים בה. ארגון הבריאות העולמי והמרכז האמריקני לבקרת מחלות העלו את המחלה לדרגת סיכון הגבוהה ביותר, בעוד שמומחים למחלות זיהומיות בישראל טוענים כי ישנה שאננות לש ממש בקרב משרד הבריאות הישראלי שכנראה אינו מודע מספיק לחשיבות הסכנה של הפטריה.
ראש איגוד המומחים למחלות זיהומיות, פרופסור גליה רהב, שיגרה פניה בנושא למשרד הבריאות לפני כשנה וחצי, אך לא זכתה במענה מיידי. משרד הבריאות מסר בתגובה כי כלל מקרי ההידבקות שדווחו ע"י המוסדות הרפואיים, טופלו בהתאם וכנדרש. לפני כמה חודשים התווספה הפטריה לרשימת המחלות הזיהומיות המחייבות דיווח מיידי של המוסדות הרפואיים, למשרד הבריאות. מידע על הידבקות שלא דווחה כראוי למשרד הבריאות, מחייב יצירת קשר מיידי עם הגורמים במשרד. החשש העיקרי כרגע בקרב המומחים למחלות זיהומיות, הוא מפני הוא מפני השתקעות קבע של המחלה בבתי החולים, בעקבות קושי למגר אותה.
מתחילים את השנה עם זכויות של זיכוי הרבים וזוכים בשפע עצום - לחצו כאן >>>
מצאתם טעות בכתבה? כתבו לנו